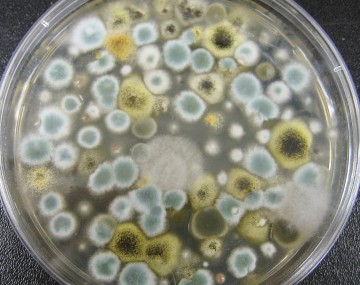
Mold growing in a petri dish

Featured Resources
Common Spring pests
Recorded presentations on Spring IPM

Webinar
In NY, spongy moth caterpillars start showing up in May. You'll learn why there are more caterpillars in some years than in others, and why you should manage them when they are still small. Also, make a plan to spend the summer preparing to...

Webinar
Got weeds? Learn how to identify common yard and garden weeds, with valuable tips for management. Then hear about best practices for keeping rats out of vegetable gardens. Weed Identification (Feature presentation) Rats in Vegetable Gardens (IPM...

Webinar
Heard the buzz about some garden pesticides being cancelled? Learn why certain pesticides were removed from the market and what you should do if you own them. Stay tuned to learn how you can help Cornell University document the distribution of...